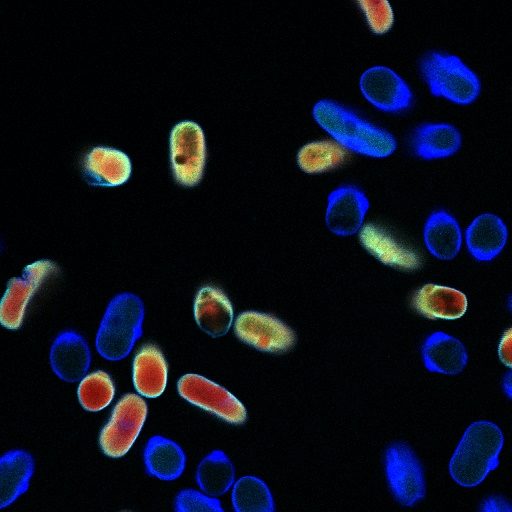

Ashley C. Smith, Ph.D.
Forensic Anthropologists, Bio-Archaeologists, and Skeletal Histologists

15
Years of Experience
9
Published Research Papers
<45
Courses Taught
About Ashley C. Smith, Ph.D.
Ashley is a highly motivated anthropologist and archaeologist specializing in forensics, osteology, and skeletal histology. She earned her Doctorate from the University of Toronto in 2025, her Master of Science degree in Forensic Anthropology from Boston University in 2012, and her Bachelor of Arts degree from the University of Memphis in 2010. Her thesis focused on histological changes in bone that can be used to assist in the assessment of the early postmortem interval. She has also publsihed research in the study of gender in the forensic/osteological record, activism in forensic science, standardization in osteometrics, and the effects of trauma in decomposition. Currently, Ashley is working on assisting in the creation of an ethical paradigm for the use of artifical intellegence in biological anthropology.
Ashley is a Fellow in the American Academy of Forensic Sciences, as well as a member in several other professional organizations. She has published 8 scholarly works, with 2 others currently under review; in addition she has presentations at 15 different conferences including the American Academy of Forensic Sciences, the American Association of Biological Anthropologists, The American Society of Bone and Mineral Research, The Internation Association of Forensic Science, and the Canadian Association of Biological Anthropologists.
Ashley has also built a significant teaching record. Sincer 2014, she has served in various teaching capacities including as a graduate teaching assistant, laboratory facilitator, and course instructor. The courses she has taught have included human osteology, forensic microscopy, forensic anatomy, foresinsic pathology, introductory and advanced forensic anthropology courses, courses in forensic best practices, disaster victim identification, introductory courses in forensic science and biological anthropology, as well as other, more advanced courses in biological anthropology and forensic science. For more than seven years Ashley has served as one of the lead facilitators of the forensic anthropological field school at The University of Toronto - Mississauga.
Ashley also serves as an active consultant. While her primary client currently is the Canadian non-profit Please Bring Me Home, Ashley has been engaged with those working with governmental agencies in Ontario, and directly such as the Waterloo and Fort Eire Police Departments, and The University of Toronto, along with non-profits such as Reuniting Families Project out of Baylor University.

Professional Highlights
Educational Background
Ashley received a Doctor of Philosophy degree at The University of Toronto in Anthropology with a specialization in evolutionary (forensic) anthropology in 2025, a Master of Science in Forensic Anthropology from Boston University in 2012, and a Bachelor of Arts from the University of Memphis in Anthropology (2010).

Case Work & Consulting
Over 10 years have worked as a self-employed consultant that has assisted with agents of from the Government of Ontario, as well as the Waterloo and Ft. Erie Police Departments. Ashley has also assisted on projects such as the Reuniting Families project out of Baylor University as well as repatriation and accession projects with The University of Toronto. Currently, she is a volunteer forensic anthropologist with the Canadian non-profit Please Bring me Home. her consulting work has been in both field services such as search and recovery in a variety of scenes, to lab work engaged in peer-review and primary analysis.

Teaching
While she has been at the University of Toronto she has been actively engaged in higher education as both a teaching assistant (laboratory faciliator) and course instructor. Over her 10 years since starting her doctoral degree, she has either served as a teaching assistant or course instructor in over 45 difference courses for close to 4,000 teaching hours between 2 institutions including the University of Toronto and Lakehead University at Orillia, Ontario. The courses she has been involved with have been varied and include topics such as human osteology, forensic microscopy, and forensic anatomy as an instructor, and field schools to introductory courses in forensic science and anthropology with the bulk of her courses being in more advanced courses in forensic methods, particularly anthropological methods and osteology as a teaching assistant and laboratory facilitator.

The Bone Club Podcast
Ashley currently co-hosts, edits, and produces The Bone Clube podcast along with her co-hosts, anthropologists Stephanie Hartley, M.Sc., and Jenna MacCrae, M.Sc. The Bone Club discusses various issues that impact the field of forensic science and anthropology, and frequently has guest to discuss different topics. Recent guests have discussed everything from the role of AI technology to the need for board certifications and the cautionary eye of mental health awareness of death responders. The Bone Club can be heard on all major and most minor podcast platforms such as Apple Podcasts, Spotify, Amazon Music, iHeartRadio, Deezer, Tune In, Pandora, Podcast Index, Listen Notes, Overcast, and others, or directly at the link below.
Professional Organizations
Over the past many years Ashley has been engaged with numerous professional organizations in both anthropology and forensics. Below are just some of the organizations in which she is currently actively engaged.
Ashley has been associated with the American Academy of Forensic Sciences since 2011 and promoted to Fellow in 2022. She served as a member of the Community Connections Committee from 2023-2026, and as a part of the Anthropology Section has served as a chair or member of 2 past ad hoc committees on membership requirements and award names, and currently serve as a member of the Member Outreach, Recruitment, Retention, and Belonging Committee.
Joined as a student member in 2009 and elevated to full member in 2016, Ashley belongs to a number of societies within the American Anthropological Association including the Biologcial Anthropology Section, the Association for Queer Anthropology, and the Society for Psychological Anthropology, as well as the Human Sexuality and Anthropology Interest Group (HSAIG)
Joining in 2011, Ashley current serves as a member of the AABA. While she has not undertaken any committee work with the AABA, she have presented at numerous conferences and has made the AABA her "second home."
Having conducted her doctoral program at the University of Toronto in Ontario, Canada, Ashley has found a special place with the CABA. First joining in 2015, she currently is a full member within the organization, and since 2022 has served on the Equity, Diversity, and Inclusion Committee, currently in the capacity as the Junior Co-Officer for the 2026-2028 term.
The MSA and MSC are two distinct organizations; one in the United States and one in Canada. In 2022 Ashley joined both the MSA and the MSC as a full member.
The Canadian Society of Forensic Science promotes forensic science education, research, and standards throughout Canada. Ashley has been a part of the CSFS as a student member since 2022.
Student Testimonials*
*Excerpts from student letters of recommendation
Cassidy Ferguson, H. B.Sc.
(University of Toronto)
As a teacher, [Ashley] provides helpful insight and advice as she always wants to see each student thrive and be successful. She teaches in manner that is efficient, thorough, and memorable. She explains complex topics with ease and creates an environment that ensures all types of learners understand the topic and/or task at hand. Ashely is patient, understanding, and very approachable. In my experience with Ashley, I have always felt comfortable asking any question and felt that she was a very personable educator.
Samantha A. Pavlidis, H. BSc.
(University of Toronto)
In my time with Ashley, I noticed that she always made time for her students. Whether it was providing long office hours, responding to emails quickly, or staying to talk with students long after class had ended, she always prioritized her students over anything else. Additionally, she has always been very open and approachable. I have a very difficult time approaching
professors and TAs for anything, but I have never once had a problem approaching Ashley to ask questions or for guidance regarding course material or just to discuss topics and ideas I found
interesting. She was always detailed when answering questions, had no problems reexplaining material in a multiple different ways until I was able to grasp it, and most importantly to me, she never once made me feel stupid or bad about asking questions and not understanding material. Ashley has proven to be a kind and encouraging person who strives to better her students and provide them with the best and most positive learning environment she can.
I would also like to note Ashley’s enthusiasm and passion while teaching. It was
immediately apparent to me that Ashley not only knew the material she was teaching but was passionate about it. She had deep understandings of the information she taught that only comes from dedicated research and genuine interest. Her love for forensics and anthropology was showcased through her excitement and enthusiasm while teaching. She easily captured my attention and made it enjoyable and interesting to learn. I have seen very few professors, let alone TAs, with the same level of passion for their craft that Ashley demonstrate in each of her classes.
Irene Bibiris, H. B.Sc.
(University of Toronto)
Since first meeting her, I have had the pleasure of having Professor Smith either as a TA or a professor throughout three courses. She has an uncanny way of breaking down course material that is both easy to understand and fun. During the Forensic Anthropology Field School, Professor Smith’s thoughtfulness and creativity aided in the development of communication during planning, searching, excavating, and documenting. This was instrumental for my team and I, resulting in us finding great success. Furthermore, Professor Smith’s role as an instructor in Human Osteology has been the most influential. Her ingenious methods of distinguishing bones have aided in my understanding and active recall.
Professor Smith’s involvement with supporting students goes beyond the classroom, expanding to mentoring and support. She has personally been available to me on multiple occasions, acting as a mentor and providing supportive advice on [personal] matters and professional advice on career choices, which have been invaluable. She demonstrates great care and passion not only for her focus of study but also for her students by constantly being available to help academically and personally.
Contact Ashley
Telephone: (647) 633-5939
E-mail: acs@ashleycsmithphd.com
Address: 5716 Chapman Avenue, Memphis, 38119, Tennessee, United States